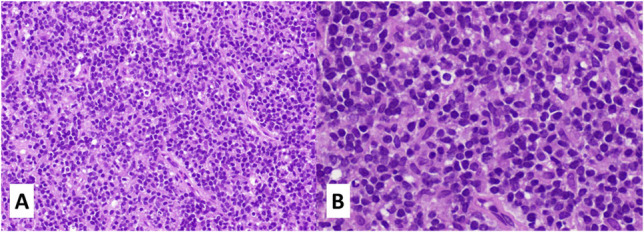

Rare extranodal NK/T-cell lymphoma: a diagnostic challenge and therapeutic approach.
Porto biomedical journal
Pub Date : 2024-11-14
eCollection Date: 2024-11-01
DOI:10.1097/j.pbj.0000000000000274
引用次数: 0

罕见结节外NK/T细胞淋巴瘤:诊断难题与治疗方法。
本文章由计算机程序翻译,如有差异,请以英文原文为准。
求助全文
约1分钟内获得全文
求助全文

 求助内容:
求助内容: 应助结果提醒方式:
应助结果提醒方式:


